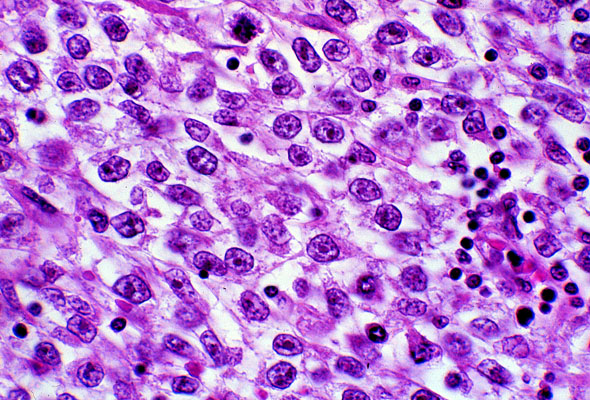

Seminoma, histology, high power
Click picture to enlarge. Close window to return
High magnification view of the tumor which is composed of clear cells. The cells have visible nuclei permanent nucleoli and clear cytoplasm. The cell membranes can be clearly seen as sharp lines. The connective tissues septum contains a small blood vessel and is infiltrated with lymphocytes.